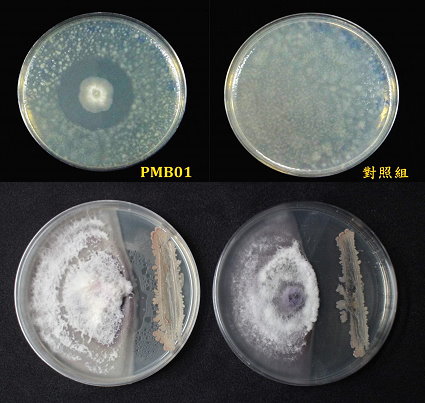
PMB01 在培養基上對青枯病菌 ( 上 ) 及萎凋病菌 ( 下 ) 具有優異的抑制效果 PMB01 在培養基上對青枯病菌 ( 上 ) 及萎凋病菌 ( 下 ) 具有優異的抑制效果

105年1月(第283期)
應用液化澱粉芽孢桿菌PMB01防治作物土壤傳播性病害
文‧圖 / 高雄區農業改良場 周浩平 陳以錚
前言
臺灣位於亞熱帶,氣候高溫多濕,各種作物病害容易發生。而土壤傳播性病害( soil-borne diseases )被認為是最難以處理的問題之一。耕作方式改變、密集連作、藥劑不當使用,以及氣候變遷等因素,皆是導致土壤傳播性病害發生日趨嚴重的原因。土壤傳播性病害初期的危害可能不明顯,但到病徵陸續顯現時,往往造成難以遏止的損傷;而在眾多土壤傳播性病害中,以青枯病( Bacterial wilt )與萎凋病( Fusarium wilt )最為棘手。該 2 類病害目前都無有效的防治方法,僅能以栽培管理方式減少病害發生,但因實際施行困難,且效果有限,目前仍被視為世界性的作物「絕症」,常讓農業專家及農友束手無策。
高雄區農業改良場(以下簡稱高雄場)在農委會「推動農業科技產業全球運籌」計畫支持下,致力開發「生物農藥用之本土液化澱粉芽孢桿菌 BaPMB01 菌株及其量產技術」。該技術對全球作物絕症病害「青枯病」與「萎凋病」防治率皆可達 70% 以上,效果令人讚嘆,現已完成技術移轉及登記,未來極具全球發展潛力。
青枯病與萎凋病
作物青枯病由植物病原細菌 Ralstonia solanacearum 所引起,該菌喜好溫暖潮濕的熱帶與亞熱帶地區,是目前世界上重要的植物病原細菌之一。青枯病為土壤傳播性病害,其可利用作物根部的接觸、種苗、機械及灌溉水等方式傳播,也可隨著流水在土壤縫隙中移動,寄主範圍超過 50 科 200 多種植物,其中以茄科作物最為重要,包括番茄、茄子及彩椒等,皆容易受其危害,青枯病於臺灣地區,每年約可造成 1,200 萬美元以上的農業損失。
作物萎凋病乃是由一種土棲性真菌-尖鐮胞菌( Fusarium oxysporum )所引起之土壤傳播性病害,該菌可產生小孢子、大孢子以及厚膜孢子,並可以產生微小的菌核。尖鐮胞菌可分解土壤中的植株殘體或有機質,並以厚膜孢子形態於土中存活;部分菌系可寄生植物體內,少部分菌株則為植物病原菌。植物病原性尖鐮胞菌具有寄主專一性,故依其寄主專一性將 F. oxysporum 區分為不同分化型( forma specialis );目前世界上有超過 100 個分化型,寄主作物涵蓋甚廣。臺灣目前紀錄顯示由尖鐮胞菌危害的作物超過 30 種,其中包括番茄、胡瓜、長豇豆及香蕉等重要作物,對農業及經濟影響甚鉅。
此 2 種病害目前皆無有效的化學防治方法,僅能以土壤處理、輪作或抗病育種等方式加以管理。然而,在田間的土壤處理效果常因各地區土壤的物理化學性質不同而出現差異,因此土壤處理的效果需長時間的評估;而輪作常需耗費多年方可達到降低病害發生的效果。抗病品種的育成與評估工作也耗時甚久,待評估之作物品種須經過嚴謹的檢定證明其抗病特性,完整評估一個品種的抗病特性是否可於田間立足,需要至少 4 年的時間;然而,一個新的抗病品種仍可能因為病原菌族群的演變或其他因素而在田間被擊倒,因此,目前亟需開發出適合有效的防治技術加以管理。
液化澱粉芽孢桿菌生物製劑的開發與應用
液化澱粉芽孢桿菌( Bacillus amyloliquefaciens )為一種好氧性格蘭氏陽性細菌, Fukumoto 首先發現並證實該細菌會產生澱粉分解酵素( amylase )及蛋白質分解酵素( protease )等多種胞外分解酵素;因生理生化反應及培養形態與枯草桿菌( Bacillus subtilis )相近,故被鑑定為一種枯草桿菌。然而,後續研究顯示該菌株在某些生理生化測試上與枯草桿菌相異,基因同源性也低於 25% ,因此 Priest 等人正式將該菌株鑑定為一新種,並命名為 B. amyloliquefaciens 。 B. amyloliquefaciens 主要分布於土壤中,根據美國食品藥品管理局( FDA )公布認證為一安全微生物( Generally Recognized as Safe , GRAS ),於農業及食品工業研究上被廣泛應用。
高雄場近年來經繁複的分離、篩選及培養基測試,自臺灣菜園中分離得到 1 株本土液化澱粉芽孢桿菌 Bacillus amyloliquefaciens PMB01 菌株。該菌株在實驗室測試中,對作物青枯病菌與鐮孢菌有優異的抑制效果;此外,其亦可產生纖維素分解酵素( cellulose )、蛋白質分解酵素( protease )、脂質分解酵素( lipase )及澱粉分解酵素( α-amylase )等,具有開發為多功能有益微生物的潛力。後續將 PMB01 針對茄科作物青枯病、胡瓜萎凋病與長豇豆萎凋病等土壤傳播性病害進行防治效果評估,經長期田間試驗後,結果顯示其對小果番茄橙蜜香及美女之防治率分別可達到 79.2 和 80.1% ;若以小胡瓜萎凋病為防治對象,當小胡瓜不處理對照組罹病度達 30.2% 時,菌液灌注處理區僅 5.6% ;以長豇豆萎凋病為防治對象時,當長豇豆不處理對照區罹病度達 29.4% 時,菌種處理區僅 3.2% ,且病勢明顯趨緩,效果極為顯著。此外, PMB01 已完成菌株之動物毒理安全評估,確認不具「口服急毒性與致病性」及「肺急毒性與致病性」,同時也已完成該菌株之全基因定序,顯示與其他液化澱粉芽孢桿菌菌株有明顯差異。未來該菌株除可發展作為青枯病與萎凋病之生物防治有機資材外,亦可望應用於製作有機肥料,或當作動物飼料添加微生物。
本項「生物農藥用之本土液化澱粉芽孢桿菌 BaPMB01 菌株及其量產技術」之專屬授權技術移轉,經農委會智慧財產權審議會審核通過後辦理公開招標,最後以新臺幣 830 萬元授權金(不含 5% 營業稅)完成技術移轉,創下國內植物保護生物之防治技轉金歷史高價紀錄。後續業完成各項生物農藥登記資料,並在各權責單位積極協助下,終於完成生物農藥登記,即將上市供農友使用,解決作物絕症病害的問題。
結語
B. amyloliquefaciens PMB01 主要功能為於田間可穩定有效地防治茄科青枯病、作物萎凋病等「絕症病害」,為作物土壤病害防治技術之重大突破,解決長期以來無防治資材可用之困境,本菌株可於作物採收期應用於其他病害之防治,減少化學農藥之使用量,改善農藥殘留過量問題;此外,並可應用於有機農業栽培,當作有機農業病害防治資材。臺灣地區青枯病與萎凋病之寄主栽培面積超過 2 萬公頃,而在全球,光番茄及胡瓜類作物之栽培面積就超過 630 萬公頃,本菌株能有效防治作物青枯病與萎凋病,經量產商品化後,將來極具全球發展潛力,且可為業者及農民創造可觀之效益。
PMB01 在培養基上對青枯病菌 ( 上 ) 及萎凋病菌 ( 下 ) 具有優異的抑制效果

PMB01 處理 ( 左 ) 在田間對防治小果番茄 ( 美女 ) 青枯病效果優異

PMB01 處理 ( 左 ) 在田間對防治小果番茄 ( 玉女 ) 青枯病效果優異

PMB01 處理 ( 左 ) 在田間對防治胡瓜萎凋病效果優異